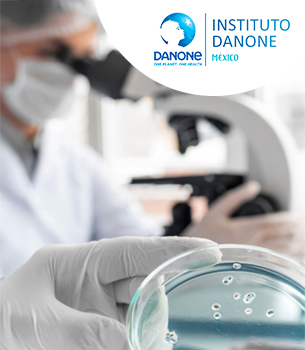

Instituto Danone
Instituto Danone México es una entidad interdisciplinaria científico-profesional creada en 1998 que nació para establecer un nexo entre los profesionales de la salud, la alimentación, la nutrición, la hidratación y la educación.
Instituto Danone México posee independencia científica, y labora sin fines de lucro. Quienes lo integran son elegidos por la comunidad científica mexicana, y trabajan en hospitales RECONOCIDOS, universidades o centros de investigación nacionales, siendo EXPERTOS en sus áreas de trabajo.
Para mayor información sobre Instituto Danone México visita http://www.institutodanone.org.mx/
¿Qué hacemos?
- Promovemos la educación médica continua de profesionales de la salud.
- Apoyamos proyectos de investigación.
- Organizamos eventos, simposios y talleres.
- Publicamos artículos científicos y libros académicos en apoyo de la nutrición en México.
- Generamos materiales educativos para profesionales de la salud y público en general.
- Desarrollamos y difundimos actividades educativas para el público en general.

Nuestros resultados
A través del Instituto Danone, apoyamos a más de 150 especialistas e investigadores mexicanos que contribuyen con su trabajo al desarrollo e investigación científica de la nutrición, la hidratación y su impacto en la salud y el bienestar.
En 2022 inauguramos, en París, Francia, el Centro de Investigación e Innovación Daniel Carasso de Danone en el campus de Paris-Saclay, dedicado al desarrollo y la innovación de nuevos productos para la alimentación del futuro.